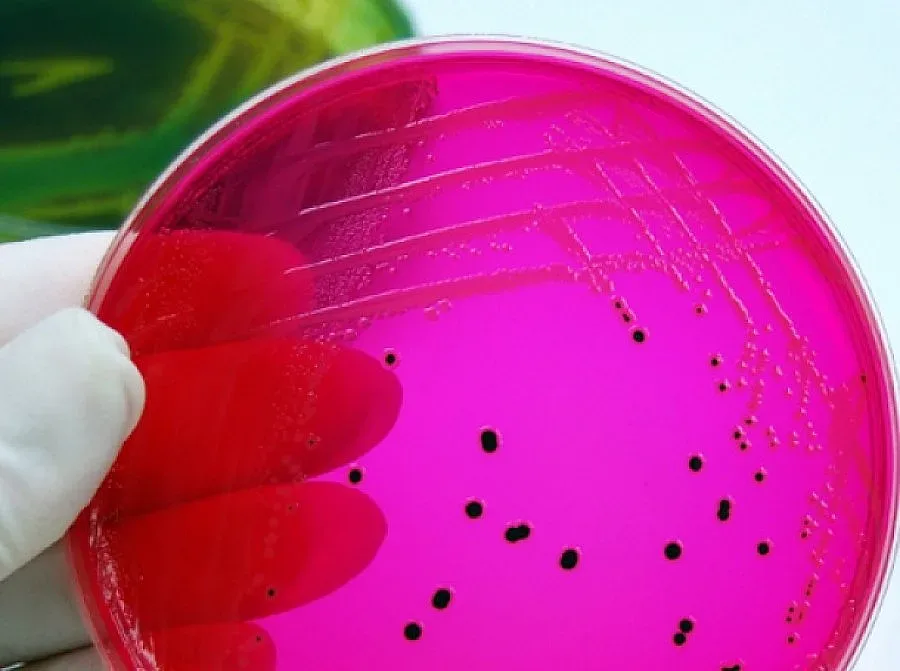

Бургас. Осем деца от лагер в Приморско са приети в болницата в Бургас с бактериално-чревна инфекция, съобщиха от МБАЛ Бургас АД. Всички те са от София.
Заразата е пламнала в хотел "Бисер", който се намира на територията на ММЦ-то. Там е почивала група от близо 100 деца на възраст от 14 до 16 години от софийски училища. Повечето от лагерниците били от английската столична гимназия. Те са се хранели в ресторанта на хотел "Бисер". Заразата тръгнала още в петък следобед, няколко часа след като малчуганите похапнали руло "Стефани" и майонеза.
По всяка вероятност яйчният сос е бил развален и е повалил децата. 7 момичета и 1 момче са откарани спешно в инфекциозното отделение на бургаската болница. Всички са имали идентични симптоми - висока температура около 40 градуса, повръщане и силно разстройство. Според медиците децата най-вероятно са пипнали салмонелоза.
"Клиничната диагноза, с която децата са приети в болницата, е бактериално-чревна инфекция с неуточнен произход. Симптомите наподобяват тези на салмонелата, но дали децата са със салмонела може да докаже единствено микробиологичният анализ, резултатите от който ще бъдат готови във вторник. Докато не бъде изолирана салмонелна бактерия, не може категорично да се твърди, че става въпрос за салмонелоза", коментираха докторите от инфекциозно отделение. Те уточниха, че децата са били в тежко състояние в събота и в неделя, но в момента състоянието им вече е значително подобрено и няма никаква опасност.
Много родители са пристигнали от София и са прибрали децата си от злополучния лагер. Хотел "Бисер" е доста стар и непретенциозен. Цените в него са възможно най-ниските и от години в него почиват предимно деца.
Последвайте ни в Google News Showcase за важните новини
Вижте всички актуални новини от Standartnews.com